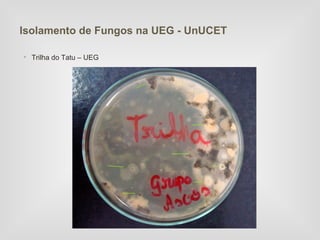
Isolamento de Fungos na UEG - UnUCET

• Trilha do Tatu – UEG
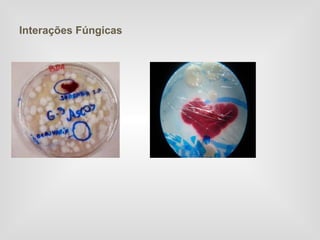
Interações Fúngicas

O documento descreve uma aula prática sobre biodegradação, fermentação e interações fúngicas realizada por acadêmicos de ciências biológicas. Vários experimentos foram conduzidos usando substratos como pão para analisar a biodegradação por fungos sob diferentes condições ambientais e a fermentação da levedura foi observada através da produção de álcool e CO2 a partir da glicose. Amostras de fungos foram também isoladas de diferentes locais no campus universitário.